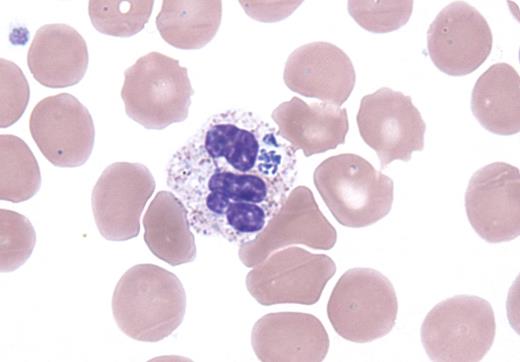
A 64-year-old man was admitted with hypotension and respiratory failure after 3 weeks of low-grade fever, cough, fatigue, intermittent sweats, chronic diarrhea, and headache. Seven years earlier he was the recipient of an unrelated bone marrow transplant for relapsed B lymphoblastic leukemia and was currently off immunosuppressive therapy. He resided in New England and was an avid hunter. His wife reported multiple tick exposures, most recently 1 week before the onset of symptoms. His white blood cell count was 19.27 × 109/L with 84% neutrophils and 14% bands, and the hemoglobin and platelets were normal. Most of the granulocytes contained intracytoplasmic inclusions (see figure). Transaminases, alkaline phosphatase, lactate dehydrogenase, and bilirubin were elevated. Creatinine was 2.09 mg/dL. PCR was positive for Anaplasma phagocytophilum. Tests for Lyme disease and babesiosis were negative. Despite broad-spectrum antibacterial therapy that included doxycycline, the patient's condition deteriorated and he died of Anaplasma sepsis 1 week later. / A phagocytophilum is the etiologic agent for human granulocytic anaplasmosis (HGA), a tick-borne illness that is endemic to New England with the highest incidence (36.5 cases per million) in Rhode Island. HGA typically presents as an acute illness with leukopenia, thrombocytopenia, and abnormal liver function tests. Thrombocytopenia is seen more frequently than leukopenia. Intracytoplasmic morulae are seen in neutrophils in 60% to 80% of cases.

A 64-year-old man was admitted with hypotension and respiratory failure after 3 weeks of low-grade fever, cough, fatigue, intermittent sweats, chronic diarrhea, and headache. Seven years earlier he was the recipient of an unrelated bone marrow transplant for relapsed B lymphoblastic leukemia and was currently off immunosuppressive therapy. He resided in New England and was an avid hunter. His wife reported multiple tick exposures, most recently 1 week before the onset of symptoms. His white blood cell count was 19.27 × 109/L with 84% neutrophils and 14% bands, and the hemoglobin and platelets were normal. Most of the granulocytes contained intracytoplasmic inclusions (see figure). Transaminases, alkaline phosphatase, lactate dehydrogenase, and bilirubin were elevated. Creatinine was 2.09 mg/dL. PCR was positive for Anaplasma phagocytophilum. Tests for Lyme disease and babesiosis were negative. Despite broad-spectrum antibacterial therapy that included doxycycline, the patient's condition deteriorated and he died of Anaplasma sepsis 1 week later.
A phagocytophilum is the etiologic agent for human granulocytic anaplasmosis (HGA), a tick-borne illness that is endemic to New England with the highest incidence (36.5 cases per million) in Rhode Island. HGA typically presents as an acute illness with leukopenia, thrombocytopenia, and abnormal liver function tests. Thrombocytopenia is seen more frequently than leukopenia. Intracytoplasmic morulae are seen in neutrophils in 60% to 80% of cases.
A 64-year-old man was admitted with hypotension and respiratory failure after 3 weeks of low-grade fever, cough, fatigue, intermittent sweats, chronic diarrhea, and headache. Seven years earlier he was the recipient of an unrelated bone marrow transplant for relapsed B lymphoblastic leukemia and was currently off immunosuppressive therapy. He resided in New England and was an avid hunter. His wife reported multiple tick exposures, most recently 1 week before the onset of symptoms. His white blood cell count was 19.27 × 109/L with 84% neutrophils and 14% bands, and the hemoglobin and platelets were normal. Most of the granulocytes contained intracytoplasmic inclusions (see figure). Transaminases, alkaline phosphatase, lactate dehydrogenase, and bilirubin were elevated. Creatinine was 2.09 mg/dL. PCR was positive for Anaplasma phagocytophilum. Tests for Lyme disease and babesiosis were negative. Despite broad-spectrum antibacterial therapy that included doxycycline, the patient's condition deteriorated and he died of Anaplasma sepsis 1 week later.
A phagocytophilum is the etiologic agent for human granulocytic anaplasmosis (HGA), a tick-borne illness that is endemic to New England with the highest incidence (36.5 cases per million) in Rhode Island. HGA typically presents as an acute illness with leukopenia, thrombocytopenia, and abnormal liver function tests. Thrombocytopenia is seen more frequently than leukopenia. Intracytoplasmic morulae are seen in neutrophils in 60% to 80% of cases.
For additional images, visit the ASH IMAGE BANK, a reference and teaching tool that iscontinually updated with new atlas and case study images. For more information visit http://imagebank.hematology.org.
This feature is available to Subscribers Only
Sign In or Create an Account Close Modal